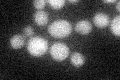
YJR110W
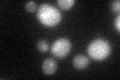
YJR110W

View description
Phosphatidylinositol 3-phosphate (PI3P) phosphatase; involved in various protein sorting pathways, including CVT targeting and endosome to vacuole transport; has similarity to the conserved myotubularin dual specificity phosphatase family
Localization:
Intensity:
Fold change:
Significance:
-
C’ GFP library in SD
cytosol22.98 -
N' NOP1pr-GFP in SD

cytosol69.7162 -
N' TEF2pr-mCherry in SD

cell periphery,vacuole65.7337 -
N' NATIVEpr-GFP in SD

below threshold21.268 -
N' TEF2pr-VC and Cyto-VN in SD

#N/A0 -
C’ GFP library in SD+DTT
cytosol25.791.12No -
C’ GFP library in SD+H2O2

cytosol26.681.16No -
C’ GFP library in Starvation Media

cytosol22.80.99No -
C’ GFP library on the background of Pup2-DaMP

cytosol -
C’ GFP library on the background of CCT mutant

cytosol24.58321.06956No
